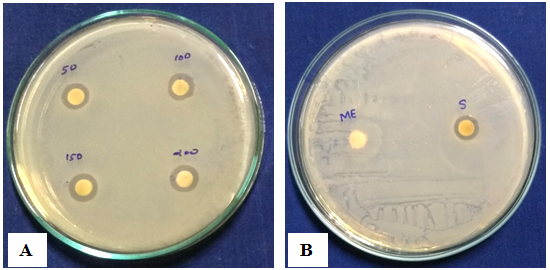
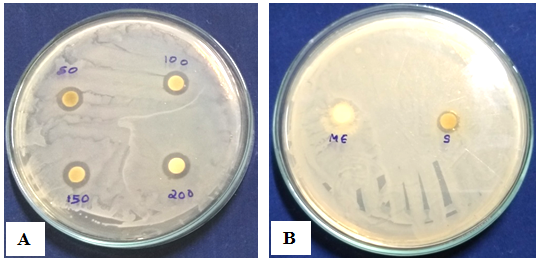
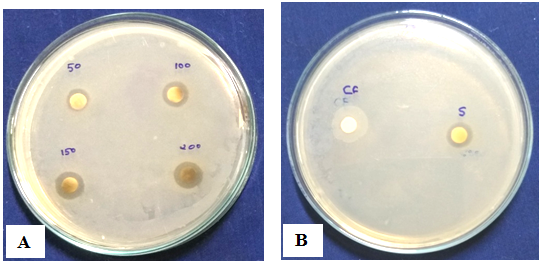
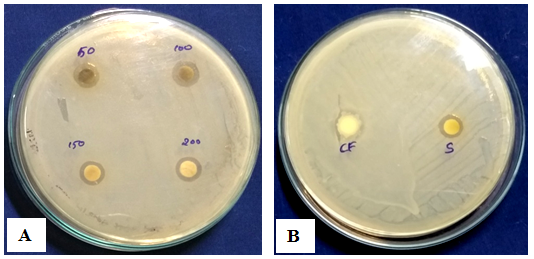
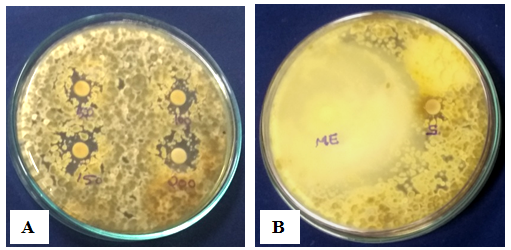
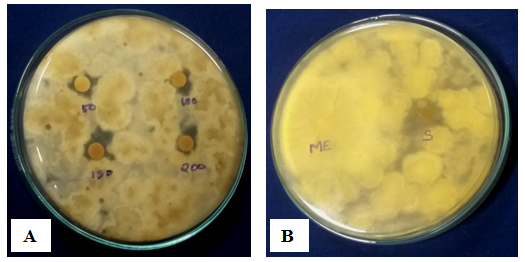
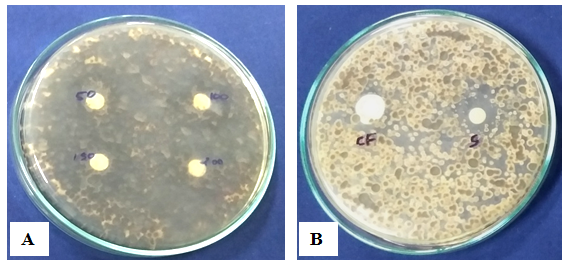
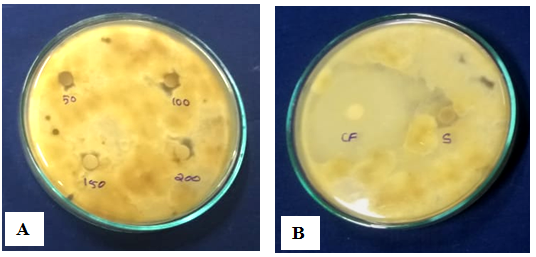

Department of Forest Pathology, Kerala Forest Research Institute, Peechi 680653, Thrissur, Kerala
Email: bharathleo5@gmail.com
Received: 10 Jul 2020, Revised and Accepted: 08 Sep 2020
ABSTRACT
Objective: Antimicrobial efficacy of silver nanoparticles from Gliocladium roseum, culture filtrate (C. F.) and mycelial mat extract (M. E.) against selected pathogens.
Methods: Culture filtrate (C. F.) and Mycelial mat extract (M. E.) of Gliocladium roseum were subjected to 10 Mm silver nitrate solution for the synthesis of silver nanoparticles. Formed silver nanoparticles were evaluated via UV-vis spectroscopy and the structural elucidation was done by FT-IR and TEM. Antimicrobial efficacy was tested against bacterial (Salmonella typhi and Klebsiella pneumonia) and fungal (Cladosporium cladosporioides and Alternaria alternata) pathogens. Different nanoparticle concentrations-50, 100, 150 and 200 µl were checked via disc diffusion method.
Results: Gliocladium roseum (C. F. and M. E.) on interaction with silver nitrate solution effectively reduced metallic silver exhibiting a colour change from yellow to dark brown within 24 h due to the formation of silver nanoparticles. The UV-vis spectrum of C. F. and M. E. showed maximum absorption peaks at 350-400 nm and 400-450 nm respectively and FT-IR and TEM showed strong N-H bonding and spherical shaped silver nanoparticles with the size of 11-19 nm (C. F.) and 25-38 nm (M. E.). Antimicrobial analysis resulted in efficient inhibitory activity against Salmonella typhi, Klebsiella pneumonia and also showed moderate inhibitory activity against Alternaria alternata and Cladosporium cladopsorioides.
Conclusion: The synthesis of silver nanoparticles from fungus Gliocladium roseum is simple, cheap, safe and eco-friendly thus emphasising on large scale scientific application.
Keywords: Gliocladium roseum, Silver nanoparticles, Culture filtrate (C. F.), Mycelial mat extract (M. E.), Antimicrobial activity
© 2020 The Authors. Published by Innovare Academic Sciences Pvt Ltd. This is an open access article under the CC BY license (http://creativecommons.org/licenses/by/4.0/)
DOI: http://dx.doi.org/10.22159/ijcpr.2020v12i6.40293. Journal homepage: https://innovareacademics.in/journals/index.php/ijcpr
Microorganisms have a salient role in the present world. They are used for various purposes in different industries like chemical industry, food industry, medicinal fields, environmental benefits etc. Despite of tremendous progress, they are deleterious to animals, human beings and plants. Human beings and plants are often infected by microorganisms such as bacteria, moulds, yeasts and viruses present in their living environments. Innovation of multiple antibiotic-resistant microorganisms as well as the appearance of undesirable side effects of certain antibiotics forced to develop new effective antimicrobial agents that can overcome the resistances of these microorganisms and are also cost-effective. Nowadays, development of nanotechnology-based medicines has opened a new territory to confront multidrug resistance in microorganisms and its alleviated obstacles [1-4].
Nanoparticles are of enormous scientific interest as they link the gap between bulk materials and atomic or molecular structures [5]. Among various nanoparticles, metal nanoparticles are the most promising ones and amid silver nanoparticles form prime product in the field of nanotechnology. Silver metal comprises strong inhibitory effect of bacterial cell as well as broad spectrum of antibacterial, antiviral, antifungal, in addition to anti-inflammatory activities [6]. Furthermore, nanosilver is comparatively less reactive than silver ions, so it is used for clinical and therapeutic applications [7, 8].
Silver nanoparticles have the ability to anchor the bacterial cell wall and actively penetrate it thereby causing structural changes in the cell membrane and it lead to the cell death. The formation of free radicals by the silver nanoparticles is scrutinized as another mechanism of cell death. Electron spin resonance spectroscopy studies revealed that formation of free radicals had the ability to damage the cell membrane and make it porous which can ultimately lead to cell death [9].
Fungi produce a large amount of nanoparticles because they can secrete large amounts of protein which is directly in cooperated with the higher productivity of nanoparticles [10]. Fungi include organisms like molds, yeasts and mushrooms; some of them may cause disease in humans and inflict losses on crops and others provide essential nutrients for the growth of the plants. Fungi are used in the production of chemicals and also in the drug manufacturing industries. The mechanism of silver nanoparticles production by fungi is trapping of Ag+ions at the surface of the fungal cell and subsequent reduction of silver ions by enzymes like napthoquninones and anthraquinones present in the fungal system [11].
Gliocladium roseum is an unusual hyphomycete that produce one-celled conidia on two distinct types of conidiophores, one penicillately branched and the other verticillately branched [12]. Gliocladium roseum is used as a biocontrol agent against various pathogens in different crops and is reported to have remarkable efficiency, dependability, cost-effectiveness, and safety in plant disease management [13-15]. The present study aimed to analyse the antimicrobial ability of bio-synthesized silver nanoparticles from Gliocladium roseum and against selected bacterial and fungal organisms.
Isolation of fungus Gliocladium roseum and production of mycelia free media
Gliocladium roseum was provided from Kerala Forest Research Institute, Peechi, Thrissur, Kerala. To prepare biomass, fungus was grown aerobically in antibiotic amended PDA medium at 25±2 °C. From the actively growing regions 10 mycelial discs (7 mm) were cut and inoculated into an Erlenmeyer flask of 250 ml capacity and incubated at 25±2 °C for 15 d. After 15 d of incubation, mycelia were separated from the culture broth by filtration through Whatman filter paper No.1. 15 ml of broth culture were filtered and the filtered broth was denoted as culture filtrate (C. F.). Separated mycelial mat was then kept for air drying. Dried mycelial mat was grinded in sterile distilled water and centrifuged at 10000rpm for 10 min. The supernatant was separated out and denoted as mycelial mat extract (M. E.).
Preparation of silver nitrate solution (10 Mm)
0.1698 gm of Silver Nitrate was added to 100 ml of sterile distilled water. Solution was stirred continuously until the silver nitrate dissolved completely. Being light-sensitive, the solution was kept in darkness and stored at 4 °C till further use.
Synthesis of silver nanoparticles
15 ml Silver nitrate solution was aseptically transferred into Gliocladium roseum mycelial mat and culture filtrate extracts. The extracts were then kept in darkness at 28 °C for seven days.
Characterization of synthesized silver nanoparticles (UV-vis spectroscopic studies)
The samples were subjected to UV visible spectra analysis on a Perkin-Elmer (lambda-25) spectrophotometer and the absorption maxima were analyzed at wavelength 300–600 nm. The de-ionized water was kept as blank.
FTIR analysis
FTIR analysis was performed on synthesized fungal (C. F. and M. E.) silver nanoparticles to identify the functional groups of the chemical components of these samples. Fourier transform infrared spectroscopy (FTIR) studies were carried out using a Bruker Vertex 70 spectrophotometer.
Transmission electron microscopy (TEM)
The size and shape of synthesized silver nanoparticles were visualized through the 200 kV Ultra High-Resolution Transmission Electron Microscope. TEM grids were prepared by placing a drop of the particles solution on a carbon-coated copper grid and drying under lamp.
Evaluation of antimicrobial activity
Test bacteria
Klebsiella pneumonia and Salmonella typhi were selected to assess the activity of silver nanoparticles because these organisms are frequently involved in hospital-acquired infections [16].
Test fungus
Cladosporium cladosporioides and Alternaria alternata were selected to assess the activity of silver nanoparticles because these organisms frequently cause plant foliar diseases [17].
Antibacterial assay
Evaluation of the antimicrobial activity of synthesized fungal silver nanoparticles (C. F. and M. E.), were carried out by disc diffusion method against two human pathogenic bacteria, namely-Klebsiella pneumonia and Salmonella typhi and two plant foliar fungal pathogens Cladosporium cladosporioides and Alternaria alternata. The discs were loaded with 50, 100, 150 and 200 µl of silver nanoparticle solution. Fungal extracts were taken as positive control and silver nitrate solution as the negative control. The Nutrient agar and Potato dextrose agar plates were swabbed with bacterial and fungal cultures, respectively. Prepared discs were placed on agar plates. Bacterial plates were incubated at 37 °C for 24-48 h and fungal plates were incubated at 25±2 °C for 7-14 d and observations were recorded.
After mixing of aqueous AgNO3, the C. F. and M. E. of Gliocladium roseum showed a colour change at room temperature from yellowish to dark brown within 24 h and later colour is due to Surface Plasmon resonance (SPR) characteristics of silver nanoparticles and control set not showed any colour change within the same environment. The presence of AgNO3 was confirmed by an Extinction spectroscopy of ultraviolet (UV) and visible (Vis) light (UV–Vis spectrum). The UV-vis spectrum of silver nanoparticles synthesised from mat extract and culture filtrate of Gliocladium roseum showed maximum absorption peaks at 350-400 nm and 400-450 nm, respectively (fig. 1 and 2).

Fig. 1: UV-vis spectra analysis of silver nanoparticles of Gliocladium roseum mycelial mat extract

Fig. 2: UV-vis spectra analysis of silver nanoparticles of Gliocladium roseum culture filtrate
The results of UV-vis spectra confirmed by using transmission electron microscope. TEM was used to view the morphology and size of silver nanoparticles. C. F. of Gliocladium roseum produced spherical-shaped nanoparticles of size 11-19 nm whereas M. E. formed nanoparticles were of 25-38 nm in size and of spherical to subspherical in shape (fig. 3 and 4).


Fig. 3: TEM analysis of silver nanoparticles of Gliocladium roseum culture filtrate


Fig. 4: TEM analysis of silver nanoparticles of Gliocladium roseum mycelial mat extract
The FTIR spectra obtained shows the spectral absorption peaks for different extracts in the region 500–4000/cm. The analysis for G. roseum C. F. revealed strong N-H group assigned to primary amines for 3448.47/cm, a weak C≡C terminal alkynes at 2075.88/cm, a medium C-N bond at 1636.74/cm, a weak N-O bond assigned to methyl group at 1385.70/cm and a medium to strong chloroalkanes or bromoalkanes group at 563.54/cm (fig. 5).

Fig. 5: FT-IR analysis of silver nanoparticles of Gliocladium roseum culture filtrate
The analysis for G. roseum M. E. revealed strong N-H group assigned to primary amines for 3448.47/cm, a weak C≡C terminal alkynes at 2075.88/cm, a medium C-N bond at 1636.74/cm, a weak N-O bond assigned to methyl group at 1384.85/cm, a medium P-C bond assigned to aromatic organophosphorus compounds at 1460.81/cm and a medium to strong chloroalkanes or bromoalkanes group at 572.13/cm (fig. 6).

Fig. 6: FT-IR analysis of silver nanaoparticles of Gliocladium roseum mycelail mat extract
Antimicrobial assay
The synthesised silver nanoparticles, fungal extracts (C. F. and M. E.) and silver nitrate solution were tested for their antimicrobial activity against two human pathogenic bacteria, Salmonella typhi and Klebsiella pneumoniae and two plant foliar fungal pathogens Cladosporium cladosporioides and Alternaria alternata by disc diffusion method using different concentrations-50, 100, 150 and 200 µl.
Antibacterial activity
Silver nanoparticles (Snp. C. F. and Snp. M. E.) of Gliocladium roseum showed considerable inhibition zone against Salmonella typhi and Klebsiella pneumoniae. Culture filtrate (Snp. C. F.) of Gliocladium roseum showed inhibition of 7 mm against S. typhi at 200 µl but against K. pneumoniae 6 mm inhibition zone was noticed. Similarly Mat extracts (Snp. M. E.) G. roseum exhibited 9 mm zone of inhibition against both the bacterial species respectively (table 1 and fig. 7-10).
Table 1: Antibacterial activity of silver nanoparticles of Gliocladium roseum against selected human pathogenic bacteria
| S. No. | Antibacterial activity of silver nanoparticles of Gliocladium roseum (mm) | ||||
| Different concentration | Salmonella typhi | Klebsiella pneumoniae | |||
| C. F. | M. E. | C. F. | M. E. | ||
| 1 | 50 | 3 | 6 | 5 | 6 |
| 2 | 100 | 5 | 7 | 5 | 7 |
| 3 | 150 | 7 | 7 | 6 | 8 |
| 4 | 200 | 7 | 9 | 6 | 9 |
| 5 | AgNO3 | 5 | 5 | 5 | 5 |
| 6 | Control | Nil | Nil | 4 | 4 |
Antibacterial activity of silver nanoparticles
Fig. 7: (A) Gliocladium roseum mycelial mat extract silver nanoparticles against Salmonella typhi (B) Control
Fig. 8: (A) Gliocladium roseum mycelial mat extract silver nanoparticles against Klebsiella pneumoniae (B) Control
Fig. 9: (A) Gliocladium roseum culture filtrate silver nanoparticles against Salmonella typhi (B) Control
Fig. 10: (A) Gliocladium roseum culture filtrate silver nanoparticles against Klebsiella pneumoniae (B) Control
Table 2: Antifungal activity of silver nanoparticles of Gliocladium roseum against selected plant foliar fungal pathogens
| S. No. | Antifungal activity of silver nanoparticles of Gliocladium roseum (mm) | ||||
| Different Concentrations | Cladosporium cladosporioides | Alternaria alternate | |||
| C. F. | M. E. | C. F. | M. E. | ||
| 1 | 50 | 4 mm | 4 mm | Nil | 4 mm |
| 2 | 100 | 4 mm | 5 mm | 3 mm | 4 mm |
| 3 | 150 | 5 mm | 5 mm | 3 mm | 5 mm |
| 4 | 200 | 5 mm | 6 mm | 4 mm | 5 mm |
| 5 | AgNO3 | 5 mm | 5 mm | 4 mm | 5 mm |
| 6 | Control | Nil | Nil | Nil | Nil |
Antifungal activity
Silver nanoparticles (Snp. C. F. and Snp. M. E.) of Gliocladium roseum were also tested for their antifungal activity against plant foliar pathogens-Alternaria alternata and Cladosporium cladosporioides. Nanoparticles of both fungal extracts showed a moderate inhibitory activity against studied pathogens (table 2 and fig. 11-14).
Antifungal activity of silver nanoparticles
Fig. 11: (A) Gliocladium roseum mycelial mat extract silver nanoparticles against Cladosporium cladosporioides (B) Control
Fig. 12: (A) Gliocladium roseum mycelial mat extract silver nanoparticles against Alternaria alternata (B) Control
Fig. 13: (A) Gliocladium roseum culture filtrate silver nanoparticles against Cladosporium cladosporioides (B) Control
Fig. 14: (A) Gliocladium roseum culture filtrate silver nanoparticles against Alternaria alternata (B) Control
Gliocladium roseum popularly, a bio-control agent, has been found associated with other peculiar abilities as well. G. roseum, an endophytic fungus, possessing different kinds of compounds that could act as mycodiesel [18] and also the ability to synthesise different compounds on different growing media exhibiting versatility of the fungus in various scientific applications [19]. Current approach evaluated silver nanoparticle production by the fungus and its antimicrobial potential. Synthesis of nanoparticle using microorganisms such as bacteria, fungi, and plants, or the byproducts of their metabolism has been described by [20]. Advantages of fungal cultures over bacteria and plants were described by [21, 22] and also they produce large quantities of proteins and enzymes, some of which can be used for the fast and sustainable synthesis of nanoparticles [23, 24]. The method of synthesis of siver nanoparticles using fungi were reported by various researchers [25-28].
Fungal culture filtrate and mat extract exhibited colour change reducing silver ions at room temperature from yellow to dark brown within 24 h and later colour is due to Surface Plasmon resonance (SPR) characteristics of silver nanoparticles [29, 30] which is correlated with the results obtained by Mukherjee et al. 2001. Silver nanoparticles production was again confirmed via UV-Vis spectrophomometry exhibiting a peak range between 350-450 charateristic to silver nanoparticle [31-33].
FTIR analysis revealed the presence of biomolecules and its different functional groups which reduce the silver nitrate and bind onto the NPs and helps in its stabilization [34, 35]. The broad band at the range of 3400 cm−1 was attributed to the–NH stretching of amines and the transmittance in this region was due to bonds with nitrogen atoms, which are the binding sites for silver [36]. The weak bands at range 2000 cm−1 and 525 cm−1 were attributed to the presence of CN and the C–O stretching of aliphatic esters [37].
On the evaluation of the formed nanoparticles via disc diffusion method over microbes exhibited varied activity with significant inhibition over bacterial agents but a moderate to low inhibition over fungal organisms. Similarly, Mat extract was found to exhibit higher inhibitory activity compared with culture filtrate more over the formed silver nanoparticle size also higher format extract compared with that of culture filtrate. Aspergillus terreus, fungus-mediated green synthesis of silver nanoparticles and its antimicrobial activity by disc diffusion assay resulted in efficient activity against various microbes namely P. aeruginosa, S. aureus, E. coli, C. albicans, C. Krusei, C. tropicalis, A. fumigates and A. flavus [38]. The antibacterial activity of silver nano partilces against various bacterial species such as P. aeruginosa, K. pneumoniae and B. Cereus etc have been reported by various authors [39, 40]. The variation in the diameter of the zone of inhibition against bacterial species may be due to the difference in their cell wall composition [41]. In vitro analysis of Trichoderma harzianum silver nanoparticles efficiently inhibited bacteria Staphylococcus aureus and Klebsiella pneumonia [41]. Efficacy of silver nanoparticles using the fungus Guignardia mangiferae was evaluated against gram-negative bacteria [42]. Aspergillus flavus nanoparticles were found to be effective in controlling the bacteria Bacillus cereus, Bacillus subtilis, Enterobacter aerogenes, Escherichia coli, and Staphylococcus aureus, with B. subtilis and E. coli being most sensitive and against the fungi Aspergillus niger and Trichoderma harzianum [43]. Aspergillus versicolor nanoparticles were found to be effective against Sclerotinia sclerotiorum and Botrytis cinerea in strawberry plants [44]. Antifungal activity of silver nanoparticles was observed against a wide range of fungi including Gloeophyllum abietinum, G. trabeum, Chaetomium globosum, Phanerochaete sordid, Fusarium oxysporum, Alternaria alternata, Sclerotinia sclerotiorum, Macrophomina phaseolina, Rhizoctonia solani, Botrytis cinerea, Curvularia lunata, Aspergillus niger, A. flavus and A. fumigatus [45-49].
Nanotechnology or Nano-science is an important branch of modern science technology with applications in different fields of science. Different types of metallic nanoparticles can be used; among them, silver nanoparticles gave emphasis to modern world because of their broad-spectrum antimicrobial potential [50-53]. Current scenario also emphasised the potentiality of Gliocladium roseum ability to synthesise silver nanoparticles and its efficacy against microbial agents emphasizing large scale industrial application but peculiarly speculating over the synthesis substrate for enhanced activity.
Characterisation of silver nanoparticles synthesised by fungus Gliocladium roseum done by various analytical methods such as UV-vis spectrophotometry, FT-IR and TEM resulted in the synthesised nanoparticles from both fungal extracts, mat extract(M. E.) and culture filtrate (C. F.) showed maximum absorption peak between the range of 350-450 nm possessing strong N-H bonding and spherical shape. We demonstrated that the antimicrobial activity of silver nanoparticle showed efficient inhibitory activity against two human pathogenic bacteria-Salmonella typhi, Klebsiella pneumonia and also showed moderate inhibitory activity against two plant foliar pathogenic fungi-Alternaria alternata and Cladosporium cladopsorioides that may suggest their future use in pharmaceutical formulation (antibacterial agents or drugs) and also emphasized in the green synthesis of silver nanoparticle with the application of fungi and can be strengthened in future studies. Further analysis for the actual mechanism of silver nanoparticles against microbes needs to be done.
The authors are grateful to the Director, KSCSTE-KFRI and to all the lab members of Forest Pathology Department, KFRI.
Nil
All the authors have contributed equally.
Declared none
Jones SA, Bowler PG, Walker M, Parsons D. Controlling wound bioburden with a novel silver-containing Hydrofiber dressing. Wound Repair Regen 2004;12:288-94.
Shahverdi AR, Fakhimi A, Shahverdi HR, Minaian S. Synthesis and effect of silver nanoparticles on the antibacterial activity of different antibiotics against Staphylococcus aureus and Escherichia coli. Nanomed Nanotechnol 2007;3:168-71.
Silva Paula MMD, Franco CV, Cesar BM, Rodrigues L, Barichello T, Savi GD, et al. Synthesis, characterization and antibacterial activity studies of poly-{styrene-acrylic acid} with silver nanoparticles. Mater Sci Eng 2009;29:647-50.
Pinto RJB, Marques PAAP, Neto CP, Trindade, T, Daina S, Sadocco P. Antibacterial activity of nanocomposites of silver and bacterial or vegetable cellulosic fibers. Acta Biomate 2009;5:2279-89.
Koushik M, Ashtaputre S, Vogel W, Urban J, Kulkarni SK, Paknikar KM. Extracellular biosynthesis of nanoparticles by sliver tolerant yeast strain MKY3. Nanotechnology 2003;14:95-100.
Evanoff I, Salopek SB. Silver nanoparticles as antimicrobial agent. A case study on E. coli as a model for gram-negative bacteria. J Colloid Interface Sci 2004;275:A177–182.
Kim JY, Sungeun K, Kim J, Jongchan L, Yoon J. The biocidal activity of nano-sized silver particles comparing with silver ion. Korean Soc. Environ Eng 2005;27:771-6.
Chen X, Schluesener HJ. Nanosilver: a nanoproduct in medical application. Toxicol Lett 2008;176:1-12.
Kim JSE, Kuk KN, Yu JH, Kim SJ, Park HJ. Antimicrobial effects of silver nanoparticles. Nanomed Nanotechnol 2007;3:95-101.
Mukherjee P, Ahmad A, Mandal D, Senapati S, Sainkar SR, Khan MI, et al. Fungus mediated synthesis of silver nanoparticles and their immobilization in the mycelial matrix: a novel biological approach to nanoparticle synthesis. Nano Lett 2001;1:515–9.
Domsch KH, Gams W, Anderson TH. Compendium of soil fungi. Academic Press, London; 1980.
Mohan YM, Raju KM, Sambasivudu K, Singh S, Sreedhar B. Preparation of acacia-stabilized silver nanoparticles: a green approach. J Appl Polym Sci 2007;106:3375–81.
Moody AR, Gindrat D. Biological control of cucumber black root rot by Gliocladium roseum. Phytopathology 1977;67:1159-62.
Pratella GC, Mari M. Effectiveness of Trichoderma, Gliocladium, and Paecilomyces in postharvest fruit protection. Postharvest Biol Technol 1993;3:49-56.
Seifert KA, Breuil C, Rossignol L, Best M, Saddler JN. Screening of microorganisms with the potential for biological control of sapstain in unseasoned lumber. Mater Org (Berl) 1988;23:81-95.
Oelschlaeger TA, Tall BD. Invasion of cultured human epithelial cells by Klebsiella pneumoniae Isolated from the Urinary Tract. Infection Immunity Am Soc Microbiol 1997;65:2950–8.
Abdullah M, Al-Sadi, Al-Alawi ZA, Patzelt A. Association of Alternaria alternata and Cladosporium cladosporioides with leaf spot in Cissus quadrangularis and Ficus sycomorus. Plant Pathol J 2015;14:44-4.
Strobel GA, Tomsheck A, Geary B, Spakowicz D, Strobel SA, Mattner S, et al. Endophyte strain NRRL 50072 producing volatile organics is a species of ascocoryne. Mycology 2010;1:187–94.
Babu PR, Sarma VV. Fungi as promising biofuel resource. New and Future Developments in Microbial Biotechnology and Bioengineering; 2019.
Duran N, Marcato PD, Duran M, Yadav A, Gade A, Rai M. Mechanistic aspects in the biogenic synthesis of extracellular metal nanoparticles by peptides, bacteria, fungi and plants. Appl Microbiol Biotechnol 2011;90:1609–24.
Gade AK, Bonde P, Ingle AP, Marcato PD, Duran N, Rai MK. Exploitation of Aspergillus niger for synthesis of silvernanoparticles. Biobased Mater Bioenergy 2008;2:243–7.
Velusamy P, Kumar GV, Jeyanthi V, Das J, Pachaiappan R. Bio-inspired green nanoparticles: synthesis, mechanism, and antibacterial application. Toxicol Res 2016;32:95–102.
Vahabi K, Mansoori GA, Karimi S. Biosynthesis of silver nanoparticles by fungus Trichoderma reesei. Insci J 2011;1:65–79.
Alghuthaymi MA, Almoammar H, Rai M, Said Galiev E, Abd Elsalam KA. Myconanoparticles: synthesis and their role in phytopathogens management. Biotechnol Biotechnol Equip 2015;29:221–36.
Costa Silva LP, Oliveira JP, Keijok WJ, Silva AR, Aguiar AR, Guimarães MCC, et al. Extracellular biosynthesis of silver nanoparticles using the cell-free filtrate of nematophagus fungus duddingtonia flagans. Int J Nanomed 2017;12:6373–81.
Guilger M, Pasquoto Stigliani T, Bilesky Jose N, Grillo R, Abhilash PC, Fraceto LF, et al. Biogenic silver nanoparticles based on Trichoderma harzianum: synthesis, characterization, toxicity evaluation and biological activity. Sci Rep 2017;7:44421.
Mekkawy AI, El-Mokhtar MA, Nafady NA, Yousef N, Hamad MA, El-Shanawany SM, et al. In vitro and in vivo evaluation of biologically synthesized silver nanoparticles for topical applications: effect of surface coating and loading into hydrogels. Int J Nanomed 2017;12:759–77.
Ottoni CA, Simões MF, Fernandes S, Santos JG, Silva ES, Souza RFB, et al. Screening of filamentous fungi for antimicrobial silver nanoparticles synthesis. AMB Express 2017;7:31.
Sanghi R, Verma P. Biomimetic synthesis and characterization of protein capped silver nanoparticles. Bioresour Technol 2009;100:501–4.
Mulvaney P. Surface plasmon spectroscopy of nanosized metal particles. Langmuir 1996;12:788.
Henglein A. Physicochemical properties of small metal particles in solution: microelectrode reactions, chemisorption, composite metal particles, and the atom-to-metal transition. J Phys Chem 1993;97:5470-1 .
Ahmad A, Mukherjee P, Mandal D, Senapati S, Khan MI, Kumar R, et al. Extracellular biosynthesis of silver nanoparticles using the fungus Fusarium oxysporum. Colloids Surf B Biointerfaces 2003;28:313.
Ingle A, Gade A, Pierrat S, Sonnichsen C, Rai M. Mycosynthesis of silver nanoparticles using the fungus Fusarium acuminatum and its activity against some human pathogenic bacteria. Curr Nanosci 2008;4:141–4.
Senapati S. Biosynthesis and Immobilization of nanoparticles and their applications. Ph. D. thesis, University of Pune; 2005.
Senapati S, Ahmad A, Khan MI, Sastry M, Kumar R. Extracellular biosynthesis of bimetallic au-ag alloy nanoparticles. Small 2005;1:517-20.
Valodkar M, Jadeja RN, Thounaojam MC, Devkar RV, Thakore S. Biocompatible synthesis of peptide capped copper nanoparticles and their biological effect on tumor cells. Materials Chem Physics 2011;128:83–9.
William DH, Fleming I. Spectroscopic methods in organic chemistry. 3rd ed. London: McGraw-Hill Book Co. (UK), Ltd; 1980. p. 1–73.
Guangquaum Li, Dan H, Yongqing Q, Wang LI. Fungus mediated green synthesis of silver nanoparticles using Aspergillus terreus. Int J Mol Sci 2012;13:466-76.
Khalil MM, Ismail EM, El-Baghdady KZ, Mohamed D. Green synthesis of silver nanoparticles using olive leaf extract and its antibacterial activity. Arab J Chem 2013;7:1131-9.
Li WR, Xie XB, Shi QS, Duan SS, Yang O, Chen YS. Antibacterial effect of silver nanoparticles on Staphylococcus aureus. Biometals 2011;24:135-41.
Keshavamurthy M, Srinath BS, Rai VR. Phytochemicals mediated green synthesis of gold nanoparticles using Pterocarpus santalinus L. (Red Sanders) bark extract and their antimicrobial properties. Part Sci Technol Int J 2017;36:7.
Ahluwalia V, Kumar J, Sisodia R, Shakil NA, Walia S. Green synthesis of silver nanoparticles by Trichoderma harzianum and their bioefficacy evaluation against Staphylococcus aureus and Klebsiella pneumonia. Ind Crops Prod 2014;55:202–6.
Balakumaran MD, Ramachandran R, Kalaicheilvan PT. Exploitation of endophytic fungus, Guignardia mangiferae for extracellular synthesis of silver nanoparticles and their in vitro biological activities. Microbiol Res 2015;178:9–17.
Elgorban AM, Aref SM, Seham SM, Elhindi KM, Bahkali AH, Sayed SR, et al. Extracellular synthesis of silver nanoparticles using Aspergillus versicolor and evaluation of their activity on plant pathogenic fungi. Mycosphere 2016;7:844–52.
Gajbhiye M, Kesharwani J, Ingle A, Gade A, Rai M. Fungus-mediated synthesis of silver nanoparticles and their activity against pathogenic fungi in combination with fluconazole. Nanomedicine: NBM 2009;5:382–6.
Gopinath V, Velusamy P. Extracellular biosynthesis of silver nanoparticles using Bacillus sp. GP-23 and evaluation of their antifungal activity towards Fusarium oxysporum. Spectrochim Acta Part A 2013;106:170–4.
Krishnaraj C, Ramachandran R, Mohan K, Kalaichelvan PT. Optimization for rapid synthesis of silver nanoparticles and its effect on phytopathogenic fungi. Spectrochim Acta Part A 2012;93:95–9.
Pinto RJB, Almeida A, Fernandes SCM, Freire CSR, Silvestre AJD, Neto CP. Antifungal activity of transparent nanocomposite thin films of pullulan and silver against Aspergillus niger. Colloids Surf B 2013;103:143–8.
Thenmozhi M, Kannabiran K, Kumar R, Khanna VG. Antifungal activity of Streptomyces sp. VITSTK7 and its synthesized Ag2O/Ag nanoparticles against medically important Aspergillus pathogens. J Mycologie Med 2013;23:97–103.
Prabhu S, Poulose EK. Silver Nanoparticles: mechanism of antimicrobial action, synthesis, medical applications, and toxicity effects. Int Nano Lett 2012;2:32.
Rai M, Kon K, Ingle A, Duran N, Galdiero S, Galdiero M. Broad-spectrum bioactivities of silver nanoparticles: the emerging trends and future prospects. Appl Microbiol Biotechnol 2014;98:1951–61.
Gupta RK, Kumar V, Gundampati RK, Malviya M, Hasan SH, Jagannadham MV. et al. Biosynthesis of silver nanoparticles from the novel strain of Streptomyces Sp. BHUMBU-80 with highly efficient electroanalytical detection of hydrogen peroxide and antibacterial activity. J Environ Chem Eng 2017;5:5624–35.
Loo YY, Rukayadil Y, Nor-Khaizura MAR, Kuan CH, Chieng BW, Nishibuchi M, et al., In vitro antimicrobial activity of green synthesized silver nanoparticles against selected gram-negative foodborne pathogens. Front Microbiol 2018;9:1555.